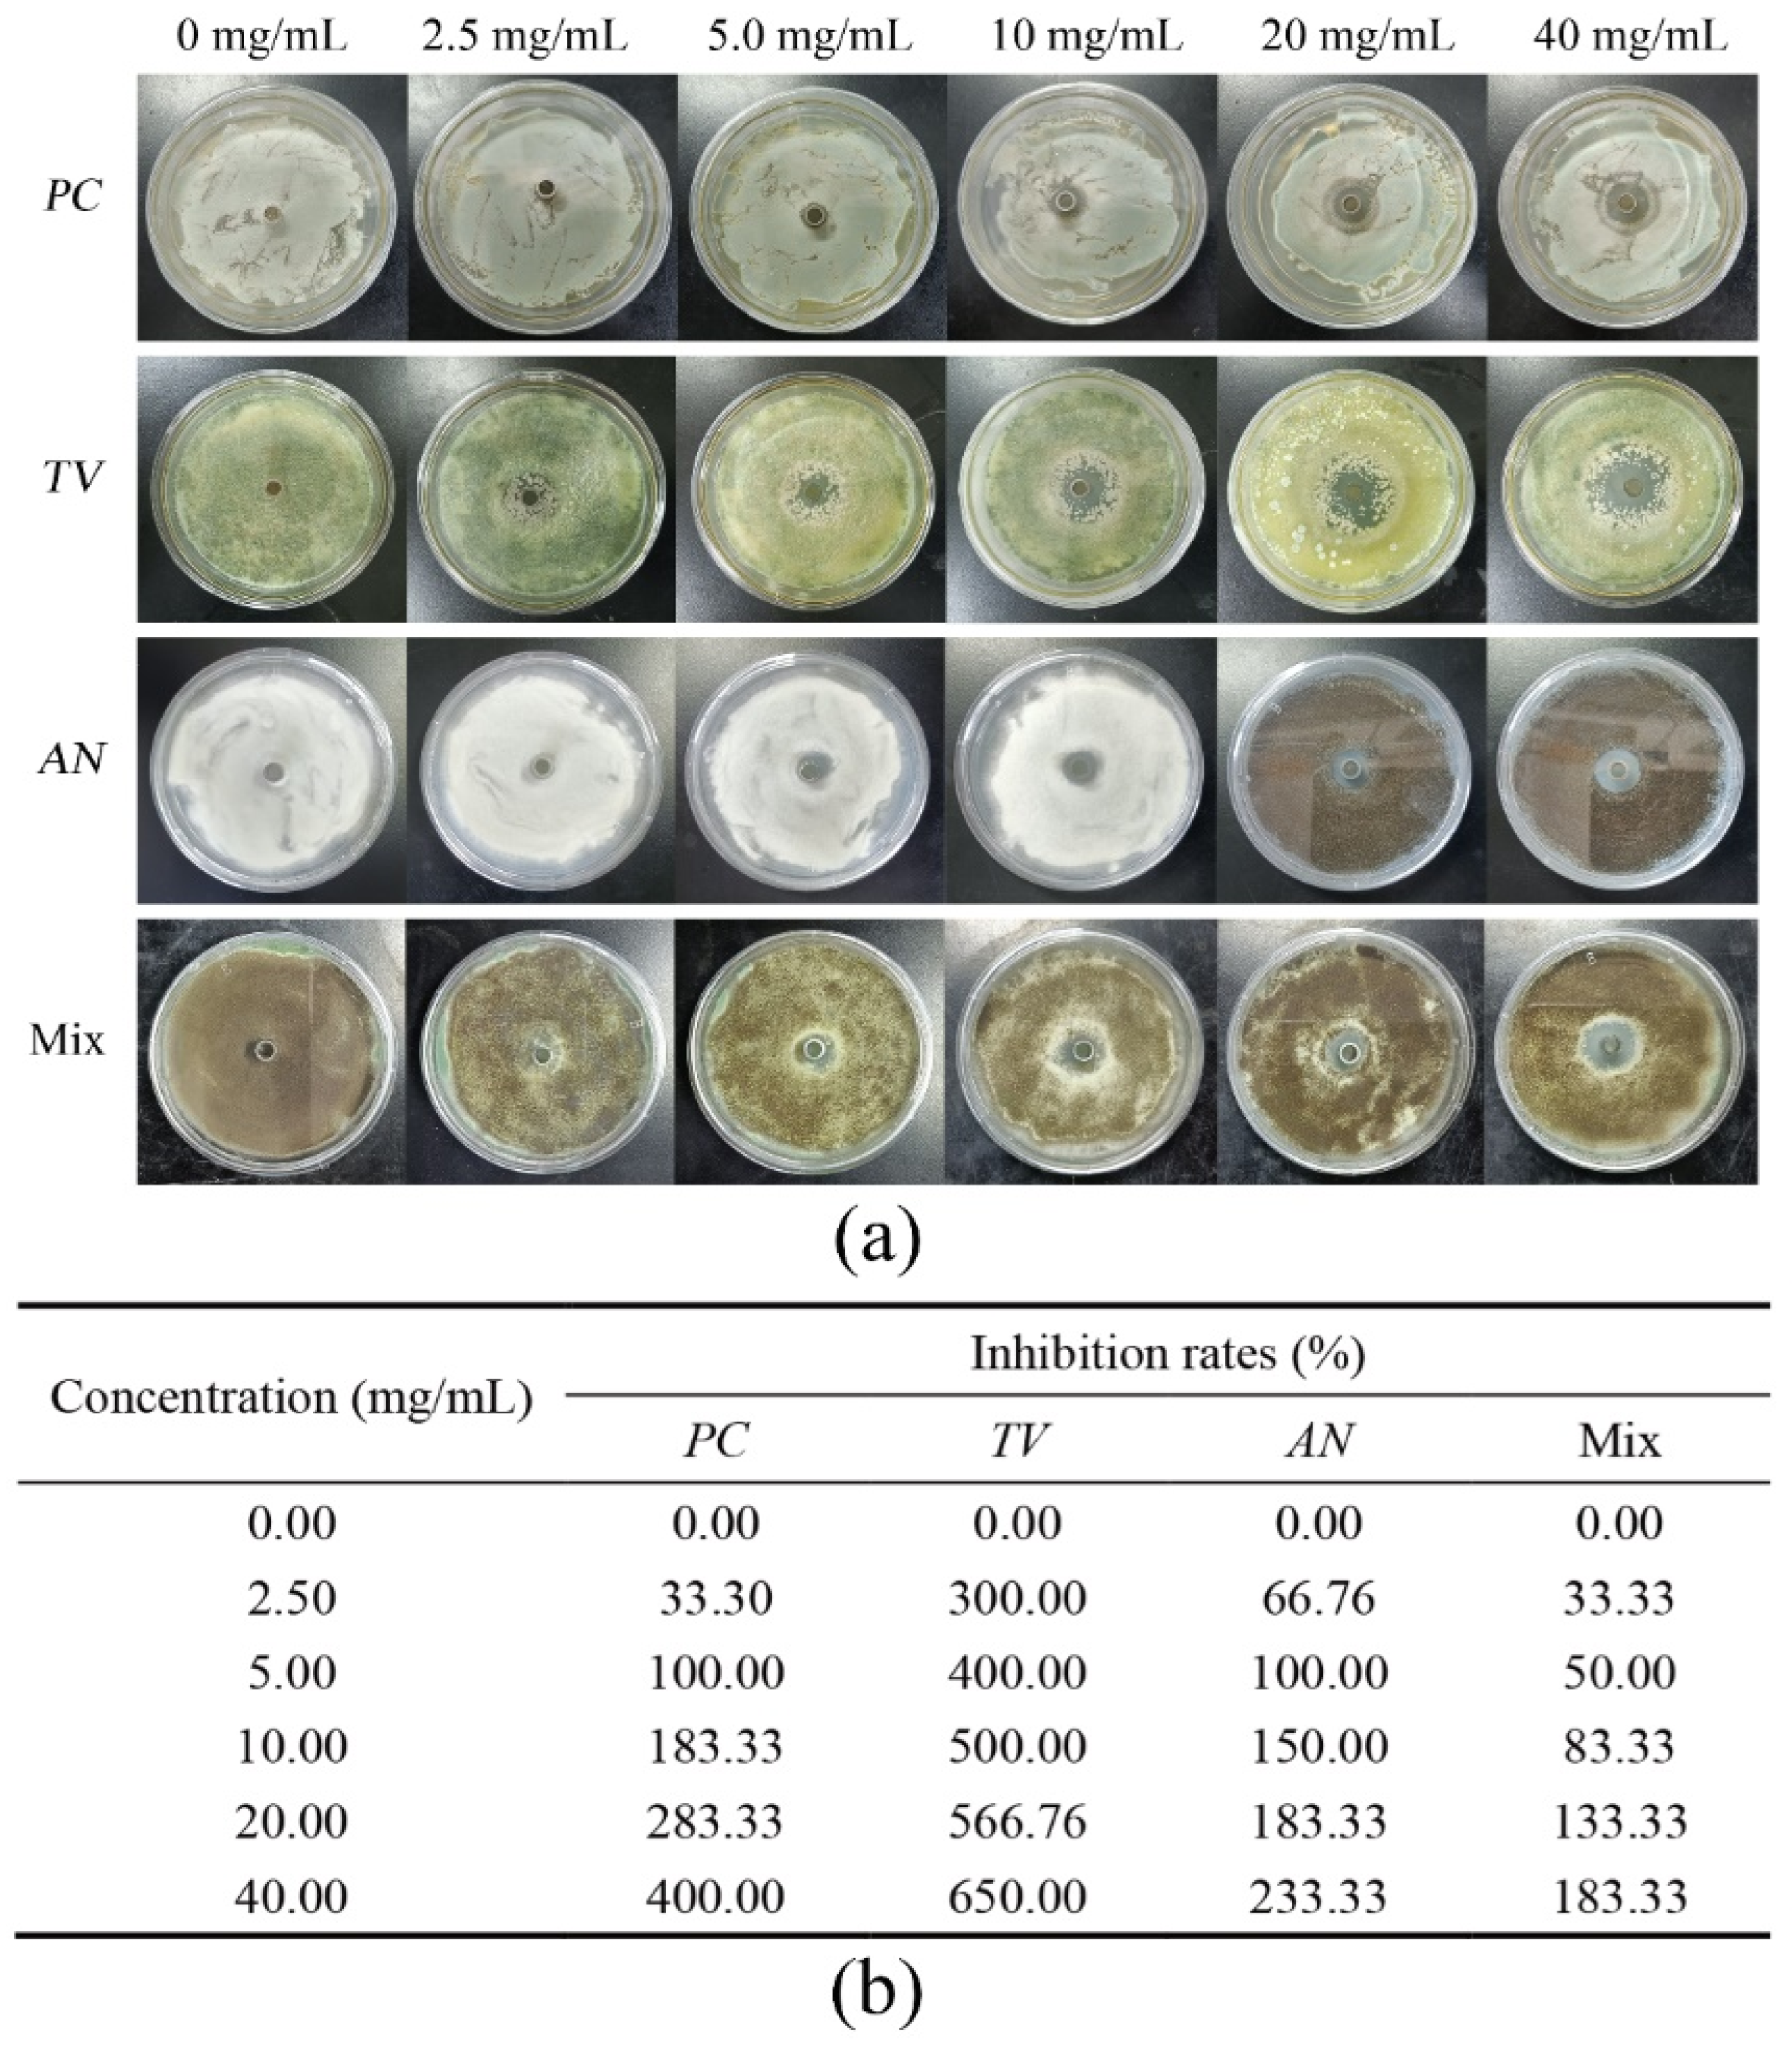
Molecules 28 03432 g001 Molecules 28 03432 g001

Screening of Ionic Liquids against Bamboo Mildew and Its Inhibition Mechanism
Abstract
1. Introduction
2. Results and Analysis
2.1. Oxford Cup Method to Investigate the Inhibition Performance of Ionic Liquids against Bamboo Mildew
2.2. Analysis of MIC and MFC Values of Bamboo Mildew
2.3. Effect of Ionic Liquid on Mycelial Morphology of Bamboo Mycorrhizal Fungi
2.4. Effect of Ionic Liquids on the Cytoarchitecture of Bamboo Mycorrhizal Fungi
2.5. Effect of Ionic Liquids on the Release of Cellular Components from Bamboo Mildew
2.6. Effect of Ionic Liquids on the Extracellular pH of Bamboo Mycorrhizal Fungi
3. Materials and Methods
3.1. Materials
3.2. Preparation of Potato Dextrose Agar (PDA)
3.3. Preparation of Microfungal Suspensions
3.4. Formulation of Ionic Liquids of Different Concentrations
3.5. Oxford Cup Method to Investigate the Inhibition Performance of Ionic Liquids against Bamboo Mildew
3.6. Minimal Inhibitory Concentration (MIC) and Minimal Fungal Concentration (MFC) Determination
3.7. Effect of Ionic Liquid on Mycelial Morphology of Bamboo Mycorrhizal Fungi
3.8. Effect of Ionic Liquids on the Microstructure of Bamboo Mildew
3.9. Effect of Ionic Liquids on the Release of Cellular Components from Bamboo Mildew
3.10. Effect of Ionic Liquids on the pH of Extracellular Fluid of Bamboo Mycorrhizal Fungi
4. Conclusions
Author Contributions
Funding
Institutional Review Board Statement
Data Availability Statement
Acknowledgments
Conflicts of Interest
References
- Barulli, L.; Mezzetta, A.; Brunetti, B.; Guazzelli, L.; Ciprioti, S.V.; Ciccioli, A. Evaporation thermodynamics of the tetraoctylphosphonium bis (trifluoromethansulfonyl) imide ([P8888] NTf2) and tetraoctylphosphonium nonafluorobutane-1-sulfonate ([P8888] NFBS) ionic liquids. J. Mol. Liq. 2021, 333, 115892. [Google Scholar] [CrossRef]
- Cao, Y.; Mu, T. Comprehensive investigation on the thermal stability of 66 ionic liquids by thermogravimetric analysis. Ind. Eng. Chem. Res. 2014, 53, 8651–8664. [Google Scholar] [CrossRef]
- Minnick, D.L.; Flores, R.A.; DeStefano, M.R.; Scurto, A.M. Cellulose solubility in ionic liquid mixtures: Temperature, cosolvent, and antisolvent effects. J. Phys. Chem. B 2016, 120, 7906–7919. [Google Scholar] [CrossRef] [PubMed]
- Sanchora, P.; Pandey, D.K.; Kagdada, H.L.; Materny, A.; Singh, D.K. Impact of alkyl chain length and water on the structure and properties of 1-alkyl-3-methylimidazolium chloride ionic liquids. Phys. Chem. Chem. Phys. 2020, 22, 17687–17704. [Google Scholar] [CrossRef] [PubMed]
- Zhencai, Q. Research Progress of Ionic Liquids in the Field of Flame Retardancy. Polym. Bull. 2020, 6, 16–25. [Google Scholar]
- Chuan, Z.; Yihe, L.; Zhenhua, J.; Gongyi, L.; Qinghua, W. Progress on imidazolium based antibacterial agents. Chem. Res. Appl. 2015, 27, 769–776. [Google Scholar]
- Li, Z.; Sun, J.; Xu, Q.; Yin, J. Homogeneous and heterogeneous ionic liquid system: Promising “ideal catalysts” for the fixation of CO2 into cyclic carbonates. ChemCatChem 2021, 13, 1848–1866. [Google Scholar] [CrossRef]
- Soares da Silva, J.P.; Soares, B.G.; Silva, A.A.; Livi, S. Double percolation of melt-mixed PS/PBAT blends loaded with carbon nanotube: Effect of molding temperature and the non-covalent functionalization of the filler by ionic liquid. Front. Mater. 2019, 6, 191. [Google Scholar] [CrossRef]
- Fallah, Z.; Zare, E.N.; Khan, M.A.; Iftekhar, S.; Ghomi, M.; Sharifi, E.; Tajbakhsh, M.; Nikfarjam, N.; Makvandi, P.; Lichtfouse, E.; et al. Ionic liquid-based antimicrobial materials for water treatment, air filtration, food packaging and anticorrosion coatings. Adv. Colloid 2021, 294, 102454. [Google Scholar] [CrossRef]
- Egorova, K.S.; Gordeev, E.G.; Ananikov, V.P. Biological activity of ionic liquids and their application in pharmaceutics and medicine. Chem. Rev. 2017, 117, 7132–7189. [Google Scholar] [CrossRef] [PubMed]
- Srisa, A.; Promhuad, K.; San, H.; Laorenza, Y.; Wongphan, P.; Wadaugsorn, K.; Sodsai, J.; Kaewpetch, T.; Tansin, K.; Harnkarnsujarit, N. Antibacterial, antifungal and antiviral polymeric food packaging in post-COVID-19 era. Polymers 2022, 14, 4042. [Google Scholar] [CrossRef] [PubMed]
- Hatzl, S.; Reisinger, A.C.; Posch, F.; Prattes, J.; Stradner, M.; Pilz, S.; Eller, P.; Schoerghuber, M.; Toller, W.; Gorkiewicz, G. Antifungal prophylaxis for prevention of COVID-19-associated pulmonary aspergillosis in critically ill patients: An observational study. Crit. Care 2021, 25, 335. [Google Scholar] [CrossRef]
- Salehi, M.; Ahmadikia, K.; Mahmoudi, S.; Kalantari, S.; Jamalimoghadamsiahkali, S.; Izadi, A.; Kord, M.; Dehghan Manshadi, S.A.; Seifi, A.; Ghiasvand, F. Oropharyngeal candidiasis in hospitalised COVID-19 patients from Iran: Species identification and antifungal susceptibility pattern. Mycoses 2020, 63, 771–778. [Google Scholar] [CrossRef] [PubMed]
- Jingkun, Z.; Haosheng, W.; Haidi, L.; Xiaofeng, W.; Renliang, Y.; Yunfa, C. Recent progress in ionic liquids as anti-microbial agent. New Chem. Mater. 2017, 45, 45–47. [Google Scholar]
- Ferraz, R.; Teixeira, V.; Rodrigues, D.; Fernandes, R.; Prudêncio, C.; Noronha, J.P.; Petrovski, Ž.; Branco, L.C. Antibacterial activity of Ionic Liquids based on ampicillin against resistant bacteria. Rsc Adv. 2014, 4, 4301–4307. [Google Scholar] [CrossRef]
- Zheng, Z.; Xu, Q.; Guo, J.; Qin, J.; Mao, H.; Wang, B.; Yan, F. Structure–antibacterial activity relationships of imidazolium-type ionic liquid monomers, poly (ionic liquids) and poly (ionic liquid) membranes: Effect of alkyl chain length and cations. ACS Appl. Mater. Interfaces 2016, 8, 12684–12692. [Google Scholar] [CrossRef]
- Reddy, G.K.K.; Nancharaiah, Y. Alkylimidazolium ionic liquids as antifungal alternatives: Antibiofilm activity against Candida albicans and underlying mechanism of action. Front. Microbiol. 2020, 11, 730. [Google Scholar] [CrossRef]
- Dong, C.; You, W.; Liuyang, R.; Lei, Y.; Zhang, A.; Lin, Y.; Polymers, F. Anti-Rhizoctonia solani activity by polymeric quaternary ammonium salt and its mechanism of action. Reactive 2018, 125, 1–10. [Google Scholar] [CrossRef]
- Zhang, L.; Feng, X.-Z.; Xiao, Z.-Q.; Fan, G.-R.; Chen, S.-X.; Liao, S.-L.; Luo, H.; Wang, Z.-D. Design, synthesis, antibacterial, antifungal and anticancer evaluations of novel β-pinene quaternary ammonium salts. Int. J. Mol. Sci. 2021, 22, 11299. [Google Scholar] [CrossRef]
- Croitoru, C.; Roata, I.C. Ionic liquids as antifungal agents for wood preservation. Molecules 2020, 25, 4289. [Google Scholar] [CrossRef]
- Li, Z.; Chen, C.; Mi, R.; Gan, W.; Dai, J.; Jiao, M.; Xie, H.; Yao, Y.; Xiao, S.; Hu, L. A strong, tough, and scalable structural material from fast-growing bamboo. Adv. Mater. 2020, 32, 1906308. [Google Scholar] [CrossRef] [PubMed]
- Li, J.; Yu, H.; Wu, Z.; Wang, J.; He, S.; Ji, J.; Li, N.; Bao, Y.; Huang, C.; Chen, Z.; et al. Room temperature synthesis of crystalline anatase TiO2 on bamboo timber surface and their short-term antifungal capability under natural weather conditions. Colloids 2016, 508, 117–123. [Google Scholar] [CrossRef]
- Li, W.; Chen, L.; Li, Y.; Li, X. Bamboo modification with 1, 3-dimethylol-4, 5-dihydroxyethyleneurea (DMDHEU) catalyzed by maleic anhydride. J. Wood Chem. Technol. 2020, 40, 126–135. [Google Scholar] [CrossRef]
- Chen, J.; Ma, Y.; Lin, H.; Zheng, Q.; Zhang, X.; Yang, W.; Li, R. Fabrication of hydrophobic ZnO/PMHS coatings on bamboo surfaces: The synergistic effect of ZnO and PMHS on anti-mildew properties. Coatings 2018, 9, 15. [Google Scholar] [CrossRef]
- Ren, D.; Li, J.; Bao, Y.; Wu, Z.; He, S.; Wang, A.; Guo, F.; Chen, Y.; Physicochemical, S.A.; Aspects, E. Low-temperature synthesis of flower-like ZnO microstructures supported on TiO2 thin films as efficient antifungal coatings for bamboo protection under dark conditions. Colloids 2018, 555, 381–388. [Google Scholar] [CrossRef]
- Meiqun, L.; Wensheng, A.; Yong, M.; Ming, Y.; Wei, H.; Jia, T.; Fei, X. Research Situation of Mildew and Antimould of Bamboo Wood. Farm Prod. Process 2015, 9, 67–70. [Google Scholar] [CrossRef]
- Wei, J.; Xu, Y.; Bao, M.; Yu, Y.; Yu, W. Effect of Resin Content on the Surface Wettability of Engineering Bamboo Scrimbers. Coatings 2023, 13, 203. [Google Scholar] [CrossRef]
- Huilong, Y.; Chungui, D.; Hongzhi, L.; Jinguang, W.; Zhongxi, Z. Advance in Anti-mildew Research of Bamboo. J. Bamboo Res. 2016, 35, 46–51. [Google Scholar]
- Longxian, R.; Guangjing, W.; Xuejian, L. Physiological Characteristics of Moulds Infecting Bamboo Wood and Mould Control. J. Cent. South For. Univ. 1997, 17, 14–19. [Google Scholar]
- Nirmala, C.; Bisht, M.S.; Bajwa, H.K.; Santosh, O. Bamboo: A rich source of natural antioxidants and its applications in the food and pharmaceutical industry. Trends Food Sci. Technol. 2018, 77, 91–99. [Google Scholar] [CrossRef]
- Zhou, Y.; Sun, F.; Bao, B.; University, F. Field tests for mold resistance with BHT and BTA added to bamboo preservatives. J. Zhejiang A 2013, 30, 385–391. [Google Scholar]
- Lusheng, Z.; Daochun, Q.; Hongling, R. Study on Mold Control Effectiveness of Bamboo Treated with Organic Fungicides. For. Mach. Woodwork. Equip. 2013, 41, 23–25+28. [Google Scholar]
- Yuan, L.; Yun, Z.; Jianbo, C.; Xianchong, S. Effects of Compound Mildew Preventives on Mildew Resistance of Medium Density Fiberboard. Guangxi For. Sci. 2019, 48, 218–222. [Google Scholar] [CrossRef]
- Curreri, A.M.; Mitragotri, S.; Tanner, E.E. Recent advances in ionic liquids in biomedicine. Adv. Sci. 2021, 8, 2004819. [Google Scholar] [CrossRef]
- Benedetto, A.; Ballone, P. Room-temperature ionic liquids and biomembranes: Setting the stage for applications in pharmacology, biomedicine, and bionanotechnology. Langmuir 2018, 34, 9579–9597. [Google Scholar] [CrossRef] [PubMed]
- Dani, U.; Bahadur, A.; Kuperkar, K.; Safety, E. Validating interfacial behaviour of surface-active ionic liquids (SAILs) with computational study integrated with biocidal and cytotoxic assessment. Ecotoxicology 2019, 186, 109784. [Google Scholar] [CrossRef] [PubMed]
- Rezki, N.; Al-Sodies, S.A.; Shreaz, S.; Shiekh, R.A.; Messali, M.; Raja, V.; Aouad, M.R. Green ultrasound versus conventional synthesis and characterization of specific task pyridinium ionic liquid hydrazones tethering fluorinated counter anions: Novel inhibitors of fungal Ergosterol biosynthesis. Molecules 2017, 22, 1532. [Google Scholar] [CrossRef] [PubMed]
- Trush, M.; Metelytsia, L.; Semenyuta, I.; Kalashnikova, L.; Papeykin, O.; Venger, I.; Tarasyuk, O.; Bodachivska, L.; Blagodatnyi, V.; Rogalsky, S.; et al. Reduced ecotoxicity and improved biodegradability of cationic biocides based on ester-functionalized pyridinium ionic liquids. Environ. Sci. 2019, 26, 4878–4889. [Google Scholar] [CrossRef]
- Yan, J.; Niu, Y.; Wu, C.; Shi, Z.; Zhao, P.; Naik, N.; Mai, X.; Yuan, B.; Materials, H. Antifungal effect of seven essential oils on bamboo. Adv. Compos. 2021, 4, 552–561. [Google Scholar] [CrossRef]
- Zhang, J.; Du, C.; Li, Q.; Hu, A.; Peng, R.; Sun, F.; Zhang, W. Inhibition mechanism and antibacterial activity of natural antibacterial agent citral on bamboo mould and its anti-mildew effect on bamboo. R. Soc. Open Sci. 2021, 8, 202244. [Google Scholar] [CrossRef]
- Sun, F.; Bao, B.; Ma, L.; Chen, A.; Duan, X. Mould-resistance of bamboo treated with the compound of chitosan-copper complex and organic fungicides. J. Wood Sci. 2012, 58, 51–56. [Google Scholar] [CrossRef]
- Anvari, S.; Hajfarajollah, H.; Mokhtarani, B.; Enayati, M.; Sharifi, A.; Mirzaei, M. Antibacterial and anti-adhesive properties of ionic liquids with various cationic and anionic heads toward pathogenic bacteria. J. Mol. Liq. 2016, 221, 685–690. [Google Scholar] [CrossRef]
- Misra, T.; Dixit, J.; Singh, S. Effect of some co-existing moulds on aflatoxin production in wheat grains under competitive environment. Indian J. Sci. Res. 2010, 1, 75–77. [Google Scholar]
- Cutter, C.N. Antimicrobial effect of herb extracts against Escherichia coli O157:H7, Listeria monocytogenes, and Salmonella typhimurium associated with beef. J. Food Prot. 2000, 63, 601–607. [Google Scholar] [CrossRef]
- Guan, M.; Zhu, Y.; Li, Y.; Wang, G.; Pan, L. Anti-mildew effect and inhibition mechanism of the slightly acidic electrolyzed water treatment of bamboo. Ind. Crops Prod. 2023, 192, 116140. [Google Scholar] [CrossRef]
- Balkan, B.; Balkan, S.; Aydoğdu, H.; Güler, N.; Ersoy, H.; Aşkın, B. Evaluation of antioxidant activities and antifungal activity of different plants species against pink mold rot-causing Trichothecium roseum. Arab. J. Sci. Eng. 2017, 42, 2279–2289. [Google Scholar] [CrossRef]
- Yang, J.; Zhang, K.-Q. Chitin synthesis and degradation in fungi: Biology and enzymes. Target. Chitin-Contain. Org. 2019, 1142, 153–167. [Google Scholar] [CrossRef]
- Djamei, A.; Schipper, K.; Rabe, F.; Ghosh, A.; Vincon, V.; Kahnt, J.; Osorio, S.; Tohge, T.; Fernie, A.R.; Feussner, I. Metabolic priming by a secreted fungal effector. Nature 2011, 478, 395–398. [Google Scholar] [CrossRef]
- Schrekker, H.S.; Donato, R.K.; Fuentefria, A.M.; Bergamo, V.; Oliveira, L.F.; Machado, M.M. Imidazolium salts as antifungal agents: Activity against emerging yeast pathogens, without human leukocyte toxicity. MedChemComm 2013, 4, 1457–1460. [Google Scholar] [CrossRef]
- Klähn, M.; Zacharias, M. Transformations in plasma membranes of cancerous cells and resulting consequences for cation insertion studied with molecular dynamics. Phys. Chem. Chem. Phys. 2013, 15, 14427–14441. [Google Scholar] [CrossRef]
- Yang, H.; Ding, H.; Zhang, X.; Luo, X.; Zhang, Y.; Physicochemical, S.A.; Aspects, E. Immobilization of dopamine on Aspergillus niger microspheres (AM/PDA) and its effect on the U (VI) adsorption capacity in aqueous solutions. Colloids 2019, 583, 123914. [Google Scholar] [CrossRef]
- Latgé, J.P. The cell wall: A carbohydrate armour for the fungal cell. Mol. Microbiol. 2007, 66, 279–290. [Google Scholar] [CrossRef]
- Wessels, J.G. Hydrophobins: Proteins that change the nature of the fungal surface. Adv. Microb. Physiol. 1996, 38, 1–45. [Google Scholar]
- Tao, N.; Duan, X.; Fan, F.; Huang, S. Inhibitory effects of citral and octanal mixture on Penicillium digitatum. Mod. Food Sci. Technol. 2015, 31, 73–76. [Google Scholar]
- Hao, Z.; Zhe, L.; Zehui, Z.; Qingling, W. Functional Analysis and Application of pH Response Factor-encoding Gene TvPacC in Trichoderma viride. Sci. Technol. Eng. 2022, 22, 15959–15966. [Google Scholar]
- Xuan, Z.; Yahong, F.; Lili, L.; Xiu, L.; Jingwen, Y.; Xiaoyu, S.; Qiongxin, L. ODC Gene Expressed Regulation of Enterobactercloacae under Different pH Conditions. Biol. Chem. Eng. 2019, 5, 90–92. [Google Scholar]
- Wu, B.; Liu, C.; Li, Q.; Li, X. Effect of pH value on folate production and gene expression of Lactobacillus plantarum. J. Anhui Agric. Univ. 2019, 46, 761–766. [Google Scholar]
- YouYuan, L.; HuaYing, Z.; WenXiao, J.; YaMin, D.; MaoRun, F. Effects of different environmental factors on the growth and acid production of Penicillium expansum and Penicillium digitatum. J. Food Saf. Qual. 2022, 13, 5044–5052. [Google Scholar] [CrossRef]
- Tan, C.; Zhu, M.; Du, S.; Yao, Y. Study on the inhibition zone method in antimicrobial test. Food Ind. 2016, 37, 122–125. [Google Scholar]
- Zhenyu, W.; Yan, W.; Qijun, A. Inhibitory Effect and Antimicrobial Mechanism of Pyrolin on Monilinia fructicola in Peach. Sci. Agric. Sin. 2009, 42, 2784–2792. [Google Scholar]
- Paul, S.; Dubey, R.; Maheswari, D.; Kang, S.C. Trachyspermum ammi (L.) fruit essential oil influencing on membrane permeability and surface characteristics in inhibiting food-borne pathogens. Food Control 2011, 22, 725–731. [Google Scholar] [CrossRef]

| Concentration (mg/mL) | MIC (mg/mL) | MFC (mg/mL) | ||||||
|---|---|---|---|---|---|---|---|---|
| PC | TV | AN | Mix | PC | TV | AN | Mix | |
| 1-Decyl-3-methylimidazole chloride | 10.15 | 2.61 | 10.08 | 20.17 | 20.09 | 10.21 | 20.13 | 40.15 |
| Benzyldimethyldodecylammonium chloride | 5.31 | 10.23 | 5.36 | 5.20 | 20.24 | 20.12 | 40.25 | 20.10 |
| Dodecylpyridinium chloride | 5.37 | 5.05 | 5.10 | 5.23 | 20.06 | 10.05 | 20.10 | 20.22 |
Disclaimer/Publisher’s Note: The statements, opinions and data contained in all publications are solely those of the individual author(s) and contributor(s) and not of MDPI and/or the editor(s). MDPI and/or the editor(s) disclaim responsibility for any injury to people or property resulting from any ideas, methods, instructions or products referred to in the content. |
© 2023 by the authors. Licensee MDPI, Basel, Switzerland. This article is an open access article distributed under the terms and conditions of the Creative Commons Attribution (CC BY) license (https://creativecommons.org/licenses/by/4.0/).
Share and Cite
Liu, C.; Chen, S.; Shan, Y.; Du, C.; Zhu, J.; Bao, Q.; Shao, Y.; Yin, W.; Yang, F.; Ran, Y.; et al. Screening of Ionic Liquids against Bamboo Mildew and Its Inhibition Mechanism. Molecules 2023, 28, 3432. https://doi.org/10.3390/molecules28083432
Liu C, Chen S, Shan Y, Du C, Zhu J, Bao Q, Shao Y, Yin W, Yang F, Ran Y, et al. Screening of Ionic Liquids against Bamboo Mildew and Its Inhibition Mechanism. Molecules. 2023; 28(8):3432. https://doi.org/10.3390/molecules28083432
Chicago/Turabian StyleLiu, Chunlin, Shiqin Chen, Yingying Shan, Chungui Du, Jiawei Zhu, Qichao Bao, Yuran Shao, Wenxiu Yin, Fei Yang, Ying Ran, and et al. 2023. "Screening of Ionic Liquids against Bamboo Mildew and Its Inhibition Mechanism" Molecules 28, no. 8: 3432. https://doi.org/10.3390/molecules28083432
APA StyleLiu, C., Chen, S., Shan, Y., Du, C., Zhu, J., Bao, Q., Shao, Y., Yin, W., Yang, F., Ran, Y., & Wang, Y. (2023). Screening of Ionic Liquids against Bamboo Mildew and Its Inhibition Mechanism. Molecules, 28(8), 3432. https://doi.org/10.3390/molecules28083432

